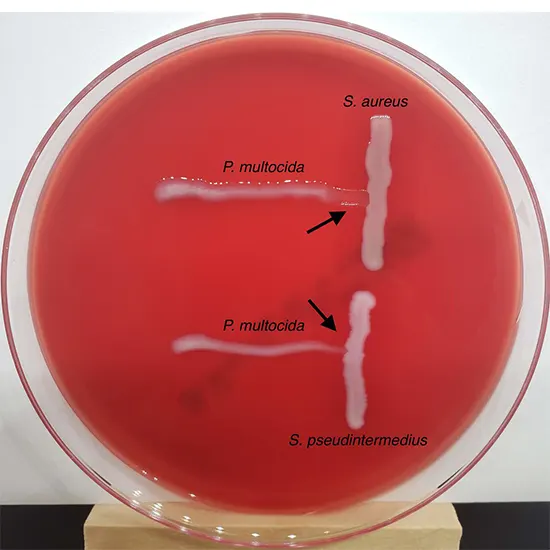

Staphylococci and group A streptococci are two of the most prevalent bacterial species that can infect people. Both types of bacteria can cause similar symptoms, such as skin infections and respiratory infections, but there...
Staphylococci and group A streptococci are two of the most prevalent bacterial species that can infect people. Both types of bacteria can cause similar symptoms, such as skin infections and respiratory infections, but there are some important differences. This is important as it may affect treatment.
1.Introduction to Group a Streptococci and Staphylococci?
Group A Streptococci and Staphylococci are two types of bacteria commonly found in the human body. Both of these types of bacteria are part of the normal flora, but they can also cause serious infections if they get into the tissues or blood.
Group A streptococcus are known to cause a variety of infections, including streptococcal pharyngitis, skin infections, and invasive infections such as necrotizing fasciitis (also known as cannibalism). This type of bacteria is also responsible for rheumatic fever, a serious condition that can damage heart valves and other organs.
Staphylococci, on the other hand, cause a variety of infections, including skin infections, pneumonia, and sepsis. Staphylococcus aureus, a type of staphylococcus, is a common cause of skin infections such as boils, impetigo, and cellulitis. MRSA (methicillin-resistant Staphylococcus aureus) is a difficult-to-treat strain of staphylococcus that is resistant to many common antibiotics.
.
2. Differences between these bacteria?
Both streptococci and staphylococci are members of the Group A bacteria and can infect people. The main differences between these two bacteria are their structure and the types of infections they commonly cause.
Streptococci are spherical and usually grow in chains. Group A Streptococcus (GAS) is a type of streptococcus that can cause a variety of infections, including streptococcal pharyngitis, impetigo, and cellulitis. Additionally, it may result in more severe illnesses including toxic shock syndrome and necrotizing fasciitis (caused by cannibalism).
Staphylococci, on the other hand, are typically round in shape and form clusters. Staphylococcus aureus is a type of staphylococcus that can cause a variety of infections, from mild skin infections such as boils and acne to more serious infections such as pneumonia and sepsis.
Another important difference between these two bacteria is their ability to produce toxins. Group A streptococci are known to produce toxins that can damage tissue and cause inflammation, whereas Staphylococcus aureus produces toxins that can lead to toxic shock syndrome and food poisoning.
In summary, both streptococcal and staphylococcal bacterial groups can cause infections, but they differ in structure, the types of infections they commonly cause, and the types of toxins they produce. Proper identification of the bacterium is important for determining appropriate treatment of infections and preventing the spread of disease.
3. Symptoms of Group A streptococcal and staphylococcal infection?
Group A streptococcal and staphylococcal infections share some similarities in symptoms, but there are also distinct differences. Group A streptococcal infections are more likely to cause sore throats, fevers, and skin infections such as impetigo and cellulitis.
Infection can also lead to more serious conditions such as sepsis, necrotizing fasciitis (also known as cannibalism), and streptococcal toxic shock syndrome Staphylococcal infections, on the other hand, depending on the illness kind, might produce a variety of symptoms.
For example, Staphylococcus aureus infections can cause skin infections such as boils, cellulitis, and impetigo, as well as food poisoning, pneumonia, and toxic shock syndrome. Commonly found on the skin.
Staphylococcus epidermidismay cause infections such as urinary tract infections, bloodstream infections and drug-related infections Implants such as catheters and artificial valves.
4. How is Group A streptococcal and staphylococcal infections diagnosed?
Diagnosing Group A streptococcal and staphylococcal infections can be difficult because symptoms can resemble those of other bacterial infections. Doctors usually begin by taking samples of the affected area for physical and laboratory tests. The sample could be a swab from a throat, wound, or skin lesion, or in more serious cases, a blood sample.
In the laboratory, samples are cultured to identify the types of bacteria present. This process involves growing the bacteria in a controlled environment and checking the types of colonies that grow. From there, various methods can be used to identify the bacterium, including biochemical testing, genetic testing, and microscopy.
In some cases, doctors may also do imaging tests, such as an X-ray of her or a CT scan of her, to see if complications or infections have spread. It's critical to receive the proper diagnosis as soon as possible so that the proper course of treatment can be initiated and others from being infected. It is crucial to see a doctor right once if you or someone you know has any suspicions that they may have Group A streptococci or staphylococci.
5. Treatment Options for Group A Streptococcal and Staphylococcal Infection?
Treatment options for Group A streptococcal and staphylococcal infection vary, but both types of infection can be serious if left untreated.
In general, antibiotics are the main treatment option for bacterial infections. The choice of antibiotic, however, is based on the particular type of bacteria causing the infection, its severity, and the patient's general condition.
For Group A streptococcal infections, penicillin or amoxicillin are usually the first line of defense. If a patient has a penicillin allergy, other antibiotics like clindamycin or azithromycin can be given instead. Hospitalization and intravenous antibiotics may be necessary in more severe situations or if the illness has spread to other bodily parts.
Antibiotics such as methicillin and vancomycin are often used for staphylococcal infections. However, antibiotic-resistant staphylococcal strains such as MRSA (methicillin-resistant Staphylococcus aureus) are on the rise.
In these cases, alternative antibiotics may be required, and hospitalization may be required for severe infections. Non-antibiotic treatment options can be used to manage symptoms and prevent complications.
For example, pain relievers and antipyretics can be used to treat symptoms of both types of infections. In severe cases, surgery may be required to empty the abscess or remove the damaged tissue. Assistance from the medical system the ideal plan of action for treating bacterial infections can be determined with the assistance of a professional.
6. How to prevent the spread of Group A streptococcal and staphylococcal infections?
To keep the public healthy, it's crucial to stop the spread of Group A streptococcal and staphylococcal infections. If not treated in a timely manner, these bacteria have the potential to cause deadly illnesses. To prevent the spread of these diseases, the following steps can be followed.
Practice good hygiene: Use soap and water to often wash your hands, especially after using the loo or after touching someone who is ill. Cover your mouth and nose when you cough or sneeze, and dispose of used tissues properly.
Cleaning and disinfecting surfaces: Regular cleaning and disinfection of frequently touched objects including doorknobs, counters, and keyboards is advised.
Avoid close contact with sick people: If you know someone who has Group A streptococcus or staphylococcus, avoid close contact with that person.
Treat infections quickly: Seek immediate medical attention if you suspect an infection with Group A streptococci or staphylococci. Early intervention can aid in limiting the spread of the infection. You can keep yourself and others healthy by adhering to these easy actions and preventing the spread of group a streptococci and staphylococci. Always keep in mind that prevention is always better than treatment.
7. Complications associated with Group A streptococcal and staphylococcal infection?
Both Group A streptococcus and staphylococci can cause serious and potentially life-threatening infections. These infections can lead to various complications, some of which are serious.
Complications associated with Group A streptococcal infection include
- Rheumatic fever that damages heart valves.
- Scarlet fever, a disease that causes skin rashes and high fever.
- An uncommon but deadly illness called streptococcal toxic shock syndrome can cause organ failure and even death.
- Necrotizing fasciitis, a rare but serious condition that destroys skin, muscle, and other tissues.
Complications associated with staphylococcal infections include
- Abscesses and boils. It might hurt and call for medical help.
- Cellulitis, a skin infection that spreads to the lymph nodes and bloodstream
- A dangerous lung infection that can be fatal is known as pneumonia.
- Toxic shock syndrome, a rare but serious condition that can lead to organ failure and death
If you suspect that you have an infection with these bacteria, it is crucial that you visit a doctor. Prompt diagnosis and treatment can effectively prevent or treat many of these complications.















